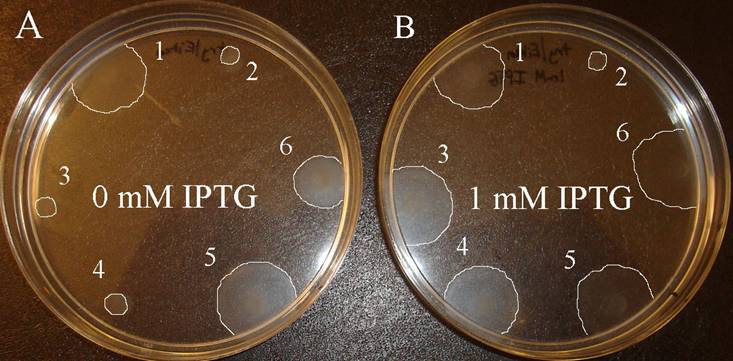

IGEM:PennState/2006/Progress motility
Swarm plate assay of Constructs C, D, and E with and without IPTG induction. Two 0.20% Eiken agar tryptone plates supplemented with Amp were used in this assay. Swarms were allowed to grow for 6 hrs. (A) Non-induced plate. (B) Plate induced with IPTG. Colony Assignments: 1, RP437 positive control; 2, RP3087 negative control; 3, RP3087 containing pDB28; 4, RP3087 containing Construct C; 5, RP3087 containing Construct D; 6, RP3087 containing Construct E. Swarms were traced using the Adobe Photoshop computer program to easily identify their sizes. Construct C swarms only on the induced plate, whereas Constructs D and E swarm on both the induced and non-induced plates.
Constructs C, D, and E, which contained Construct B and constitutively expressed lacI, were built to determine the effect of increased repressor concentration on the output device. Based on the results of the assay, Construct C was the only device shown to have an effective immotile state. The pLacIQ promoter used in this construct proved to be the only promoter strong enough to produce LacI at a concentration sufficient to fully repress cell motility in the non-induced state. It was also concluded that the pKat promoter used in Construct E was strong enough to produce a less effective “off” state. This was proven by the fact that colony on the non-induced plate was noticeable smaller than the colony on the induced plate. The pCat promoter used in Construct D was not strong enough to even slightly repress the swarming phenotype in the non-induced state.